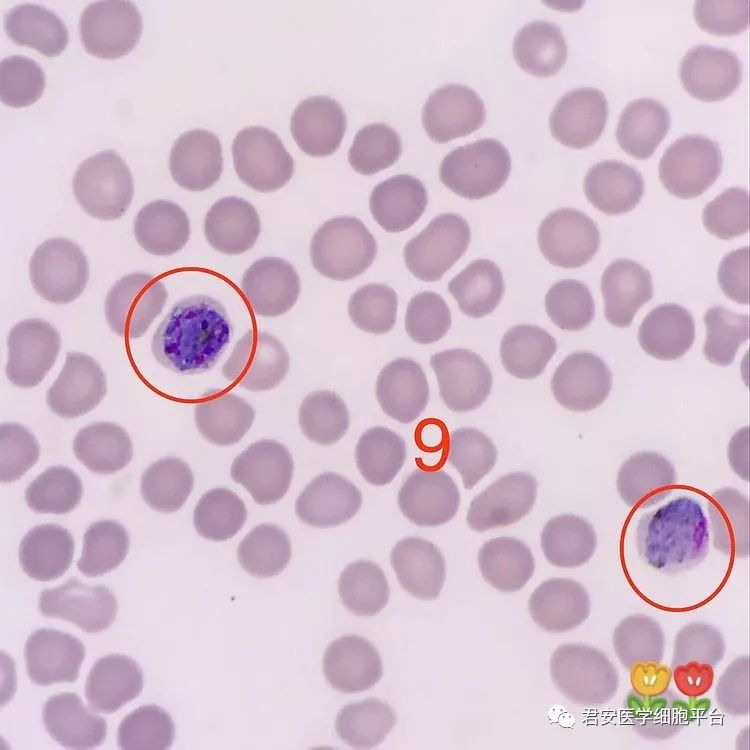
▼「(左)疟原虫未成熟裂殖体(右)疟原虫雌配子体」形态特征:(左)

海带雌配子体

海带配子体克隆杂交试验"海嘉1号"海带新品系规模化育苗建设凡纳滨
图片尺寸1080x711
海带
图片尺寸499x514
及其制备方法和应用,具体涉及将抗除草剂的bar基因导入海带雌配子体中
图片尺寸1000x397
cn102660648b_一个海带雌配子体特异性分子标记fsml-1488的染色体定位
图片尺寸448x490
grain,花粉粒; st,stomium,气孔; t:绒粘层; tds: tetrads,四分体; v
图片尺寸1240x1715
划时代的植物产物种子丨凡此种种
图片尺寸559x252
▼「(左)疟原虫未成熟裂殖体(右)疟原虫雌配子体」形态特征:(左)
图片尺寸750x750
海带如何繁殖?
图片尺寸720x472
可以游动,一天后鞭毛脱落,附着到岩礁上发育成丝状的雌,雄配子体,两种
图片尺寸480x513
柳树的复杂世代交替:雌配子体又称大配子体(megagametophyte),即子房
图片尺寸499x575
p.f 雌配子体8.p.f 雄配子体7.p.f 环状体6.p.v 雌配子体5.p.
图片尺寸3389x3024
最终研发成功一种新型的"配子体采苗育苗技术",培育出的海带产量,出成
图片尺寸660x495
海带属生活史
图片尺寸300x294
恶性疟原虫雄配子体▼恶性疟原虫雌配子体▼恶性疟原虫环状体▼间日
图片尺寸1080x1079
海带生活史是不等世代交替,包括无性世代的孢子体和有性世代的配子体
图片尺寸805x1176
大滋养体,未成熟裂殖体,成熟裂殖体)间日虐原虫(雄配子体,雌配子体)
图片尺寸848x500
具体详情如下:海带它是营养价值很高的蔬菜,同时有一定的药用价值
图片尺寸500x360
有了青蒿素离彻底消灭疟疾那天还远吗
图片尺寸582x776
孢子体
图片尺寸150x128
人体寄生虫学实验报告 - 知乎
图片尺寸3024x4032